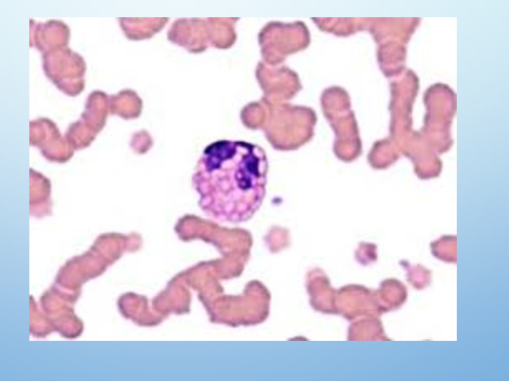
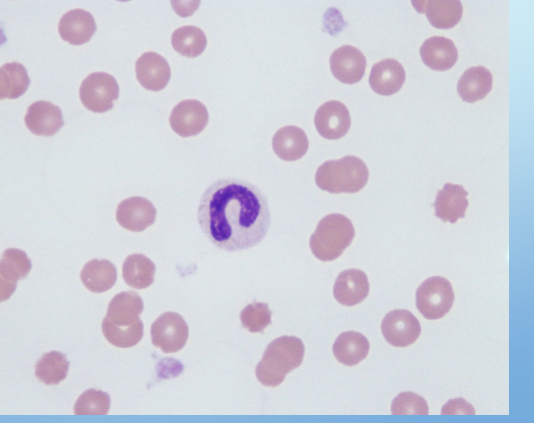
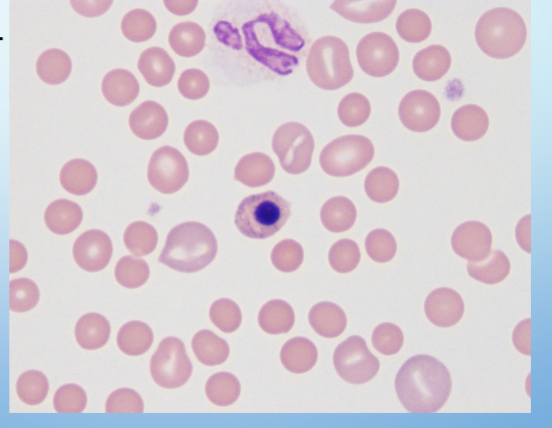

This canine ECG at 25 mm/sec is demonstrating:
1. atrial fibrillation
2. ventricular tachycardia
3. sinus arrhythmia
4. normal sinus rhythm

- normal sinus rhythm
or 3. sinus arrhythmia
NOT: 1. atrial fibrillation or 2. ventricular tachycardia
- idk the actual answer but AI says it’s most likely this. Or “narrow-complex tachycardia”
Why:
Regular rhythm
HR is WNL
No known heart condition
What is your interpretation of this test result? (instructions “fell off”)
1. patient is positive for FIV
2. patient is positive for FeLV
3. undetermined, the test failed its controls
4. patient is positive for both FeLV and FIV

- patient is positive for FIV
Identify the ova in this canine fecal sample. You may use the reference provided in this question. (Hint: assume 40x objective for this degree of clarity)
A, B, & C

a. Toxocara canis
b. Nanophyetus salmincola
c. Trichuris vulpis
Identify the long purple structure in the center of this canine hematology sample.
1. microfilaria of Dirofilaria
2. cotton fiber
3. Thelazia
4. Ancyclostoma

- microfilaria of Dirofilaria
Interpret this canine Heartworm test pictured below.
C = control T= Patient Sample
1. Positive for Heartworm Disease
2. Negative for Heartworm Disease
3. Invalid

- Positive for Heartworm Disease
T/F: If a blood pressure cuff is too small, it will result in artifact lowering of the blood pressure reading.
False.
Too small = Higher reading
Too large = Lower reading
What is the titer for the sample indicated by this dilution diagram?
a. 1:160
b. 160
c. 1:320
d. it cannot be determined from this diagram

a. 1:160
Which statement about chemical reagent strip analysis of urine is true?
1. the urine must be a room temperature for accurate results
2. specific gravity is most accurate using the reagent strip
3. timing is not important
4. supernatant of spun urine must be used
- the urine must be a room temperature for accurate results
The heart rate of this patient is ___bpm. (paper speed 25 mm/sec)
a. 100 bpm
b. 80 bpm
c. 200 bpm
d. it can’t be determined from this image

a. 100 bpm
Correct placement of the EKG sensors(clips) with correctly color-coded wires is…
Right Front leg:
Left Front leg:
Right Rear leg:
Left Rear leg:
RF: White
LF: Black
RR: Green
LR: Red
What is the specific gravity of this urine sample as read on the refractometer below?

1.045
The dog in this Neuro Exam is being allowed to fully weight bear.
1. What is the name of this test?
2. What is your interpretation of the result based on this photo?

- Conscious proprioception
- Severe, does not appear to be repositioning the paw back onto the floor.
- Identify the equine white blood cell.
- Describe this white blood cell’s function.
- Eosinophil
- Fights parasites and mediates allergic inflammatory reactions
Function of each:
1. Neutrophil
2. Eosinophil
3. Monocyte
4. T-Lymphocytes (in peripheral blood)
5. B-Lymphocytes (in lymph nodes)
Hint: “part of inflammation” is not an answer!
- Phagocytize & destroy foreign particles with chemicals such as H2O2.
- Fight parasites & lead allergic reactions.
- Phagocytize foreign material & present antigen to lymphocytes.
- Lymphs can’t function without them!
- Mono’s in tissue are called Macrophages - Cellular immunity.
- Against infected cells or cancer. - Produce antibodies.
- Identify the canine white blood cell.
- Describe the morphology
- Band neutrophil
- Mild toxic change indicated by open chromatin and “ground glass” cytoplasm
This is a fine needle aspirate of canine gastric wall with a diagnosis of gastric adenocarcinoma.
List four features evident on this slide that support the diagnosis of malignant process. (7)

- Prominent multiple nucleoli
- Nuclear size variation (anisokaryosis)
- High N:C ratio
- Anisocytosis (variable cell sizes)
- Pleomorphism (variable cell shapes)
- Darkly blue staining cytoplasm
- Course open chromatin
This canine patient has regenerative anemia. List the three features seen on this slide that specifically support the diagnosis of regenerative anemia.
(Do not describe morphology that doesn’t specifically support “regenerative anemia.”)
- Nucleated red blood cell (specifically metarubricyte)
- Polychromasia of red cell population
- Anisocytosis (some red cells are quite large and bluish)
A new blood test for canine lymphoma has been developed. In a study of 100 dogs with confirmed lymphoma, the test was positive in 95 dogs. In a separate study of 100 healthy dogs, the test was positive in 5 dogs.
a. What is the sensitivity of this test?
b. What is the specificity of this test?

a. 95%
b. 95%
Describe the use of this Jamshidi Needle in veterinary medicine

For the collection of bone marrow aspirate and/or bone marrow biopsy
What is the difference between U-40 and U-100 insulin? (Be very specific)
U-40= 40 units/1 ml
U-100= 100 units/1ml
Therefore U-100 is more concentrated than U-40
The DVM has ordered 27 U of NPH U-100 insulin for a Schnauzer named Mitzie.
How many ml of insulin will you administer if no insulin syringes are available?
0.27mL
27u / U-100 = 0.27mL
U-100 is the concentration of insulin and 27u is the desired amount.
Desired / Storage concentration = Volume
Describe the steps of administering insulin to a Medical Boarding stable diabetic patient (5)
- Verify the patient/insulin type/dose administration/route.
- Roll insulin gently to mix.
- Draw up insulin dose and verify order, vial and draw with colleague
- Verify pet is eating just prior to injection (i.e. canned food)
- Administer route per orders, drawing back to confirm “no blood” prior to injecting


